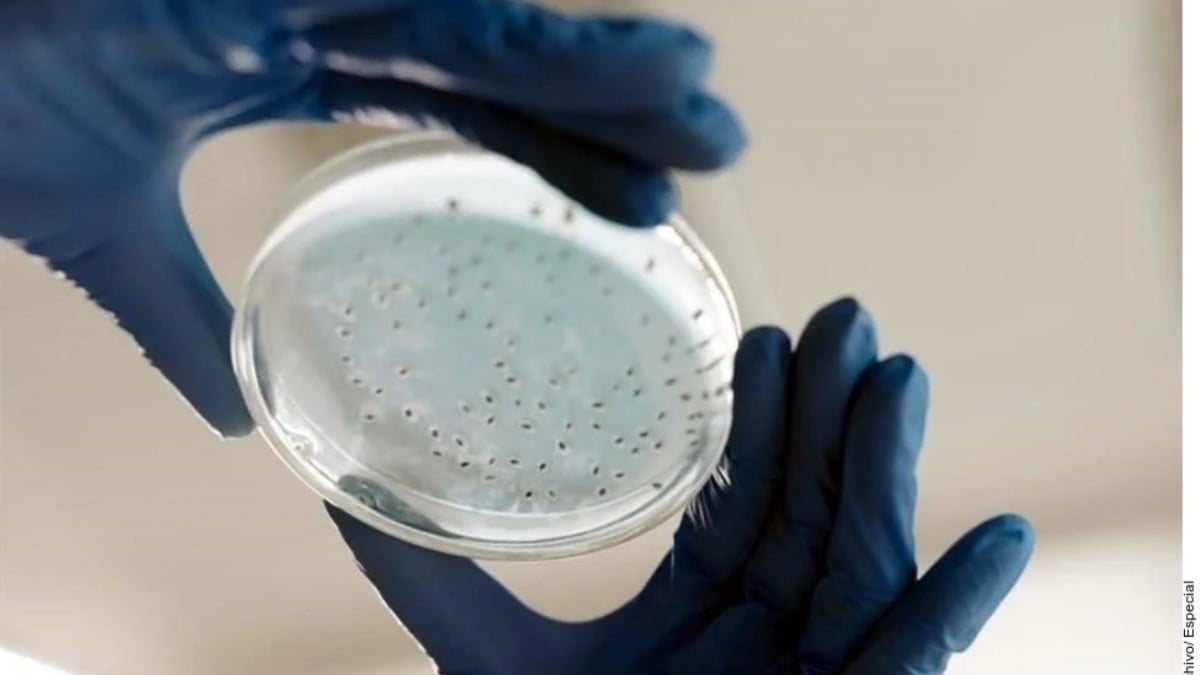
Secretaría de Salud aún no tiene confirmación de 6 casos de bacteria asesina en Guanajuato

Guanajuato - La Secretaría de Salud estatal no tiene confirmación de seis infecciones relacionadas con la bacteria klebsiella oxytoca en Guanajuato, una de ellas con desenlace fatal, como lo afirmó el secretario de Salud federal, David Kershenobich, durante la conferencia matutina.
El sector salud estatal aclaró que solo podrá confirmar los casos una vez que el Instituto de Diagnóstico y Referencia Epidemiológicos (INDRE) concluya la investigación que lleva a cabo sobre los reportes en la entidad.

Da click aquí y suscríbete a nuestro canal de Whatsapp e infórmate de todo lo que necesitas saber
Se tienen en investigación y análisis seis casos que están siendo examinados en el Instituto de Diagnóstico y Referencia Epidemiológicos”, explicó la Secretaría de Salud del Estado de Guanajuato.
En la red de hospitales del sector salud se difundió la alerta emitida por la Federación, reforzando la vigilancia integral de los pacientes y fortaleciendo las acciones epidemiológicas para la búsqueda activa y su notificación, informaron.
Te recomendamos: ¡Ojo aquí! Detectan brote de bacteria asesina en Guanajuato, ya murió un menor de edad
Dice Salud estatal que esperará resultados del INDRE para confirmar casos
Pese a reconocer la posibilidad de infecciones relacionadas con klebsiella oxytoca, reiteraron que es necesario esperar los resultados del INDRE para confirmar los casos.
Ante los hechos ocurridos en el Estado de México relacionados con la alerta epidemiológica por la infección de klebsiella oxytoca, asociada con la posible contaminación de nutrición parenteral o insumos relacionados, en Guanajuato sigue vigente la alerta y vigilancia en las unidades médicas”, añadieron en un comunicado.
El documento no especifica si los casos se identificaron en uno o varios hospitales ni las ciudades de origen. Tampoco aclara si corresponden a instituciones de la red estatal de salud o de la federación.
Sobre la bacteria klebsiella oxytoca
La klebsiella oxytoca es una enterobacteria gramnegativa que se encuentra de forma habitual en el tracto gastrointestinal de humanos y animales. Sin embargo, es una bacteria oportunista que puede causar infecciones intrahospitalarias en pacientes inmunocomprometidos.
Entre las infecciones más comunes asociadas a esta bacteria se encuentran:
- Infecciones del tracto urinario
- Neumonías
- Infecciones del torrente sanguíneo
- Infecciones en la piel y tejidos blandos
Estos datos fueron difundidos por las autoridades de salud para generar conciencia sobre la naturaleza y riesgos de la bacteria.